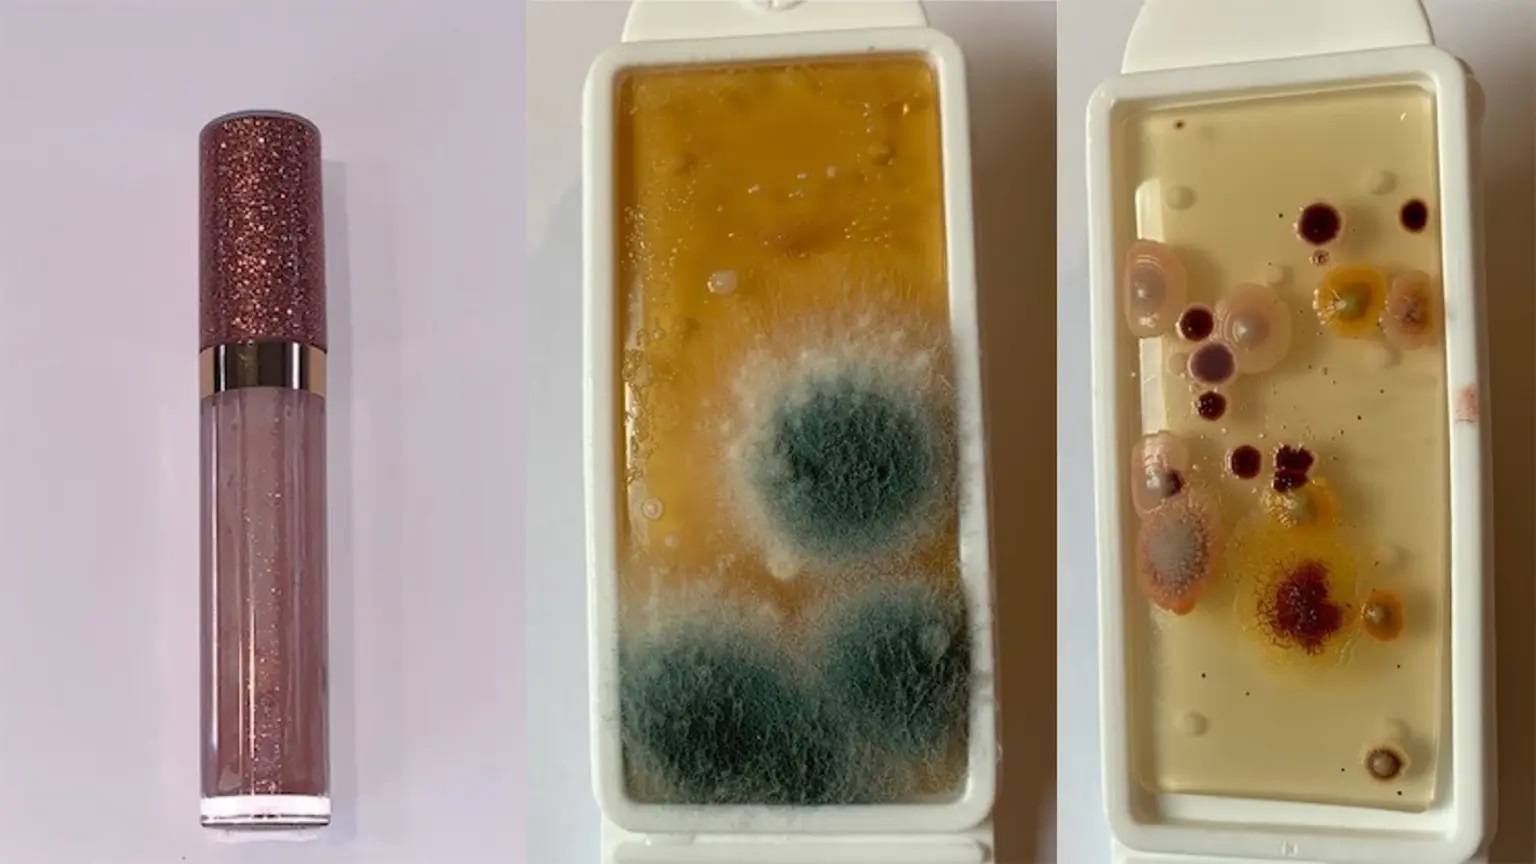

صور مجهرية مثيرة للاشمئزاز تُظهر “فُرَشَ المكياج” أقذر من المراحيض!

هوية بريس – وكالات
كشفت دراسة جديدة أن فرش المكياج يمكن أن تحتوي على بكتيريا أكثر من فرشاة المرحاض.
وتُظهر الصور المروعة الصادرة عن عيادة Aventus Clinic المتخصصة في الأمراض الجلدية ومقرها في هيتشن بهيرتفوردشاير، كيف أن فرش المكياج والأدوات المتسخة مغطاة بالفعل بالعفن الغامض والفطريات والبكتيريا.
Makeup brushes are dirtier than toilets, disgusting microscopic photos show https://t.co/mMAKnXx9z8 pic.twitter.com/vsGxp664yz
— New York Post (@nypost) April 14, 2022
وقام الفريق بمسح فراشي الماكياج لمعرفة ما يكمن تحت السطح المجهري. ومن بين 12 فرشاة وقع اختبارها، تبين أن 11 فرشاة أكثر اتساخا من متوسط مقعد المرحاض، مع كون أدوات ظلال العيون وأحمر الخدود هي الأسوأ.
Been grossing my team out all day with stories I’ve signed of mangled penises (the photos are… horrific) people masturbating with unusual items and mouldy make-up brushes.
So, I thought I’d do the same with you lot. Enjoy these @jampressltd gems.https://t.co/HfhMTaKZVW
— Almara Abgarian (@almaraabgarian) April 14, 2022
وكان ملمع الشفاه، ثالث أدوات المكياج اتساخا في القائمة، حيث عثر على 4364 مستعمرة من الخميرة والبكتيريا في جميع العناصر التي وقع اختبارها.

وتعرض كل مجموعة من الصور المنتج الذي تم اختباره، وعلبة تظهر مستوى العفن والخميرة، وأخرى بها البكتيريا.
وكانت علبة اختبار فرشاة ظلال العيون مغطاة بالكامل تقريبا بقالب أزرق وأخضر غامض، بينما تحتوي علبة فرشاة الأساس على قطرات كبيرة من البكتيريا ذات الدم الأحمر.


وقد يكون استخدام فرش المكياج المتسخة ضارا ويسبب الالتهابات وتشققات الجلد.
وقال الدكتور سهيل علم، المدير الطبي في Aventus Clinic: “إنه لأمر مروع أن نرى كمية البكتيريا التي يمكن أن تعلق على فرشاة المكياج”.
وحتى بعد استخدام فرشاة مكياج لأول مرة، فإنها ستشكل بالفعل مستعمرات من البكتيريا.

ومع الاستخدام اليومي، ستبدأ الفرشاة تلقائيا في جمع الأوساخ والملوثات والزيوت وخلايا الجلد الميتة، ولهذا تعمل فرش المكياج كأرض خصبة للبكتيريا التي يمكن أن تؤدي إلى ظهور البثور وتهيج الجلد.
ويشيرالدكتور علم: “إذا لامست الفرشاة الملوثة العين، فقد يتسبب ذلك في حدوث عدوى أو تفاعلات حساسية ولكن يمكن تجنب ذلك من خلال روتين التنظيف الأسبوعي”.
ونوصي بتنظيف فرش المكياج مرة واحدة على الأقل في الأسبوع لتجنب مثل هذا التراكم الهائل للبكتيريا.
ولتنظيف الفرشاة بشكل صحيح، نقترح ترغية الفرشاة في منظف مناسب للبشرة، وتدليك أي شعيرات في راحة اليد جيدا، وشطفها بالماء الفاتر، ثم عصر الفرشاة لإزالة أي رطوبة زائدة.
وكلما قمت بتنظيف الفرش، قلّ تسرب الأوساخ من الشعيرات، ولذلك لا ينبغي التوقف عن تنظيف الفرش بانتظام.



